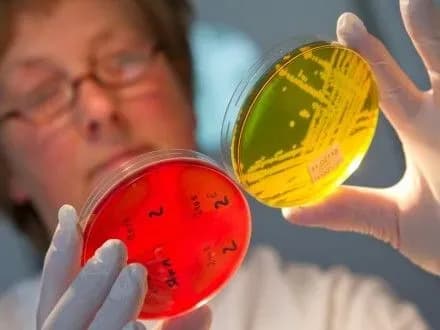
До лікарів після отруєння в Ізмаїлі звернулося 769 людей - ДСНС

До лікарів після отруєння в Ізмаїлі звернулося 769 людей - ДСНС
Київ • УНН
КИЇВ. 29 червня. УНН. Протягом 16-28 червня з попереднім діагнозом "гострий гастроентероколіт" до Ізмаїльської районної лікарні звернулося 769 людини, з них 447 дітей, з міста Ізмаїл та села Броска Ізмаїльського району на Одещині, досі в медичних закладах міста перебуває 98 осіб, 74 з яких - діти. Про це УНН повідомили у прес-службі ДСНС.
"Протягом 16-28 червня до Ізмаїльської районної лікарні з попереднім діагнозом – гострий гастроентероколіт звернулося 769 осіб (з них 447 дітей) місцевих мешканців міста Ізмаїл та села Броска Ізмаїльського району", - йдеться у повідомленні.
Також вказано, що станом на 7 годину 29 червня в медичних закладах Ізмаїла перебуває 98 осіб, з них 74 дитини.
Фахівцями СЕС здійснюється комплекс санітарно-епідеміологічних заходів. Попередня причина захворювання – споживання недоброякісної води.